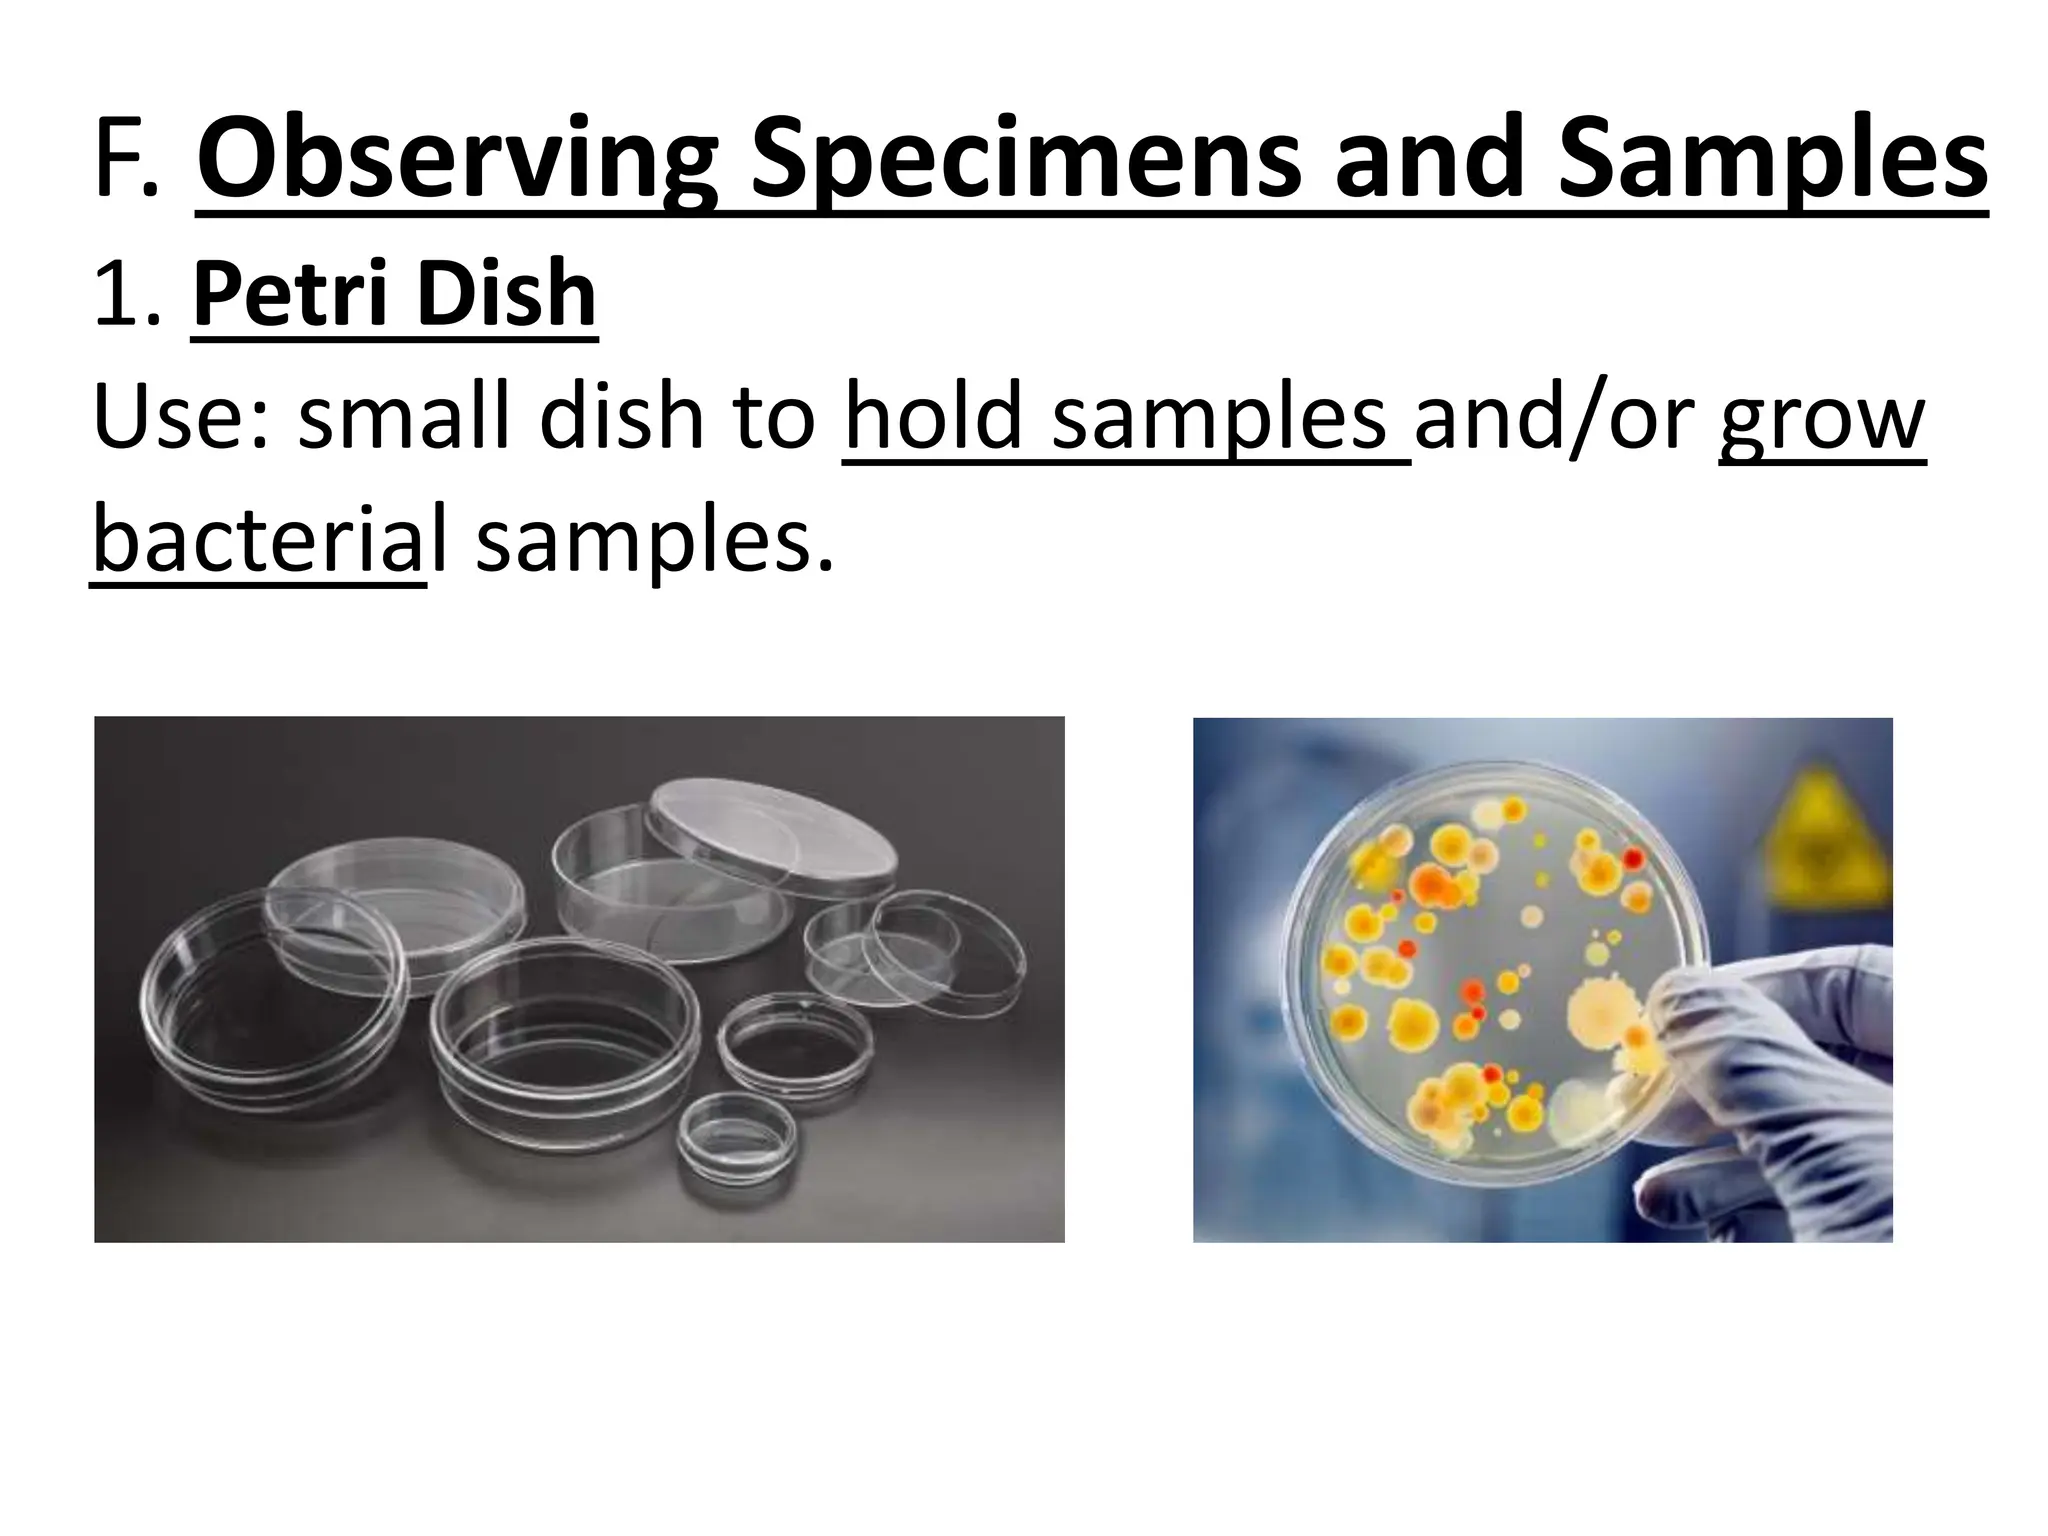
F. Observing Specimens and Samples
1. Petri Dish
Use: small dish to hold samples and/or grow
bacterial samples.

The document describes various tools and equipment used by biologists in the laboratory, including tools for measuring length and volume, dissection, observing specimens under the microscope, handling chemicals, and safety equipment. Key pieces of equipment are graduated cylinders and pipettes for measuring volume, balances for measuring mass, microscopes for examination, and safety goggles and gloves for protection. The document provides instructions for using these tools properly.